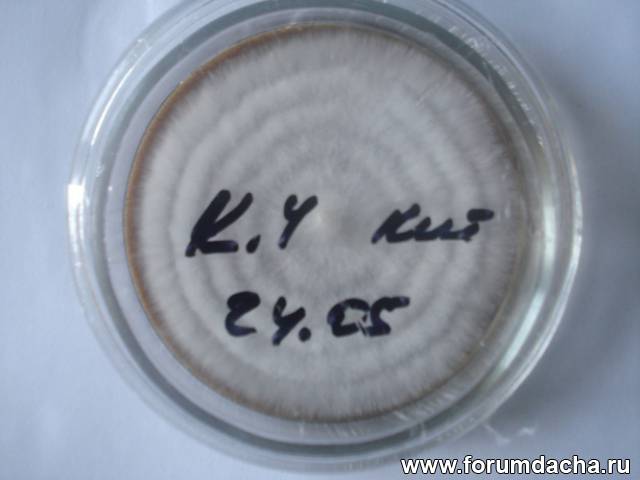

|

| Автор |
Сообщение |
Александр Кузнецов |
|
|
Зарегистрирован: 23.10.2009
Сообщения: 6770
Откуда: Алтайский край, р.ц.Алтайское
|

|
01-06-2012, 13:51 |
 Заголовок сообщения: |
| Александр Дворянинов писал(а): |
| Александр Кузнецов писал(а): |
Александр Дворянинов
Александр Геннадьевич, посмотрите как дойдут образцы? Если что-не так время ещё есть.. Или потом при второй волне плодоношения можно повторить отправку образцов? |
Не переживайте Александр Иванович, к встрече образцов я готов, всё будет нормально. приложу для этого все мои знания и опыт.
Если что будет не так в доставке, в дальнейшем исправим ошибки. |
Да, я это и имел ввиду. Что надо выработать простую и надежную схему отправки материала от Веселки.. Ввиду её специфики со споровой жидкостью..
А завтра попробую подстраховаться, и насушить "шляпок" со спрорами. И запаяю в пакет. Пусть лежит для страховки. А может и отправлю сразу?
|
|
Александр Кузнецов |
|
|
Зарегистрирован: 23.10.2009
Сообщения: 6770
Откуда: Алтайский край, р.ц.Алтайское
|

|
01-06-2012, 13:58 |
 Заголовок сообщения: |
| snowbarsik писал(а): |
замороженным наверно дороговато будет
дешевле нанять орду местных бабушек что бы искали грибы на месте.
у меня примечено место где в прошлом году осенью была замечена весёлка если удастся перенести её к себе на участок и это будет какая то другая весёлка непременно вышлю образцы |
В том и фокус. Я специально выкладывал фото из Сети.. http://foto.mail.ru/community/sad-i-mikoriza/Phallus_impudicus
И складывается впечатление, что видов (подвидов) очень много.. Вот и надо попытаться собрать коллекцию из разных мест..
А потом попытаться определить полезные свойства видов.. Уже их плодовых тел, это одно.. И влияние их (видов) на растения (и на предмет симбиоза)..
Поэтому, старайтесь найти местные виды.. И попытайтесь потом материал отправить в Банк культур..
|
|
Александр Дворянинов |
|
|
Зарегистрирован: 30.05.2012
Сообщения: 482
|

|
01-06-2012, 13:59 |
 Заголовок сообщения: |
| Paul писал(а): |
| Да. Если посылка с мицелием отправлена зимой. На почте при пересылках в вагонах не отапливают, а следовательно низкие темп-ры могут быть губительны. |
Мне известен случай, когда несколько тонн мицелия, при транспортировке в фуре зимой, при внешней температуре -5*С , Воронеж - Брянск, после доставки не дали никаких всходов, оптимальная температура хранения или перевозки +3, +5*С.
Последний раз редактировалось: Александр Дворянинов (01-06-2012, 14:06), всего редактировалось 1 раз
|
|
Александр Дворянинов |
|
|
Зарегистрирован: 30.05.2012
Сообщения: 482
|

|
01-06-2012, 14:06 |
 Заголовок сообщения: |
| Александр Кузнецов писал(а): |
| Да, я это и имел ввиду. Что надо выработать простую и надежную схему отправки материала от Веселки.. Ввиду её специфики со споровой жидкостью.. |
Я считаю, то что Вы отправили будет достаточным для выделения культуры в чистом виде, сухой шляпкой тоже надёжно. Я почему то уверен. Время покажет.
|
|
Александр Дворянинов |
|
|
Зарегистрирован: 30.05.2012
Сообщения: 482
|

|
01-06-2012, 14:16 |
 Заголовок сообщения: |
Обращаюсь к форуму!
Может кто то встречал в своём регионе, Весёлку Адриана?
Было бы не плохо сохранить её в нашем банке, и потом желающим форумчанам вырастить её на своём участке. Она меня просто завораживает, глядя на фото яйца.
|
|
Александр Дворянинов |
|
|
Зарегистрирован: 30.05.2012
Сообщения: 482
|

|
01-06-2012, 14:20 |
 Заголовок сообщения: |
| Александр Кузнецов писал(а): |
| А в меду- запросто! |
Александр Иванович опишите пожалуйста, как Вы отпраляли в меду?
В каком ? И как отправлять в меду черенки? Можно ссылку где написано.
|
|
А.Ю. |
|
|
Зарегистрирован: 02.05.2011
Сообщения: 182
Откуда: Москва
|

|
01-06-2012, 16:17 |
 Заголовок сообщения: |
Хорошая идея - банк грибов.
По ходу тоже буду пробовать получить мицелий из спор, тяжей и кусочков плодовых тел. К моменту прочтения этой темы я уже заготовил все необходимой для сооружения главбоквса - камеры позволяющей стерилизовать и проводить работы по заражению мицелием различные среды в стерильных условиях, так сказать лаборатория на столе. Очередь за малым - за самими грибами 
В конце июня опять начну поиски.
Как найду гриб, да получу из него мицелий - обязательно поделюсь.
Жаль, у нас в Подмосковье Веселки хрящеватой вроде бы нет. А было бы хорошо если бы была, поскольку она начинает плодоносить раньше Веселки обыкновенной.
А чем Веселка Адриана отличается от Веселки обыкновенной? На вид она самая.
|
|
Александр Дворянинов |
|
|
Зарегистрирован: 30.05.2012
Сообщения: 482
|

|
01-06-2012, 16:32 |
 Заголовок сообщения: |
| А.Ю. писал(а): |
Как найду гриб, да получу из него мицелий - обязательно поделюсь.
Жаль, у нас в Подмосковье Веселки хрящеватой вроде бы нет. А было бы хорошо если бы была, поскольку она начинает плодоносить раньше Веселки обыкновенной.
А чем Веселка Адриана отличается от Веселки обыкновенной? На вид она самая. |
Так банк грибов для этого и создаём, что бы от каждого по возможности и каждому желаемое.
Вот ссылка на описание Весёлки Адриана:
http://nekrosbog.ucoz.ru/publ/griby/griby_ukrainy_sedobnye/veselka_adriana/15-1-0-198
|
|
А.Ю. |
|
|
Зарегистрирован: 02.05.2011
Сообщения: 182
Откуда: Москва
|

|
01-06-2012, 16:55 |
 Заголовок сообщения: |
| Александр Дворянинов писал(а): |
Так банк грибов для этого и создаём, что бы от каждого по возможности и каждому желаемое. |
Александр , на сколько я понял пока в банке веселки нет?
Значит дорога одна - в лес.
Я даже заказал себе GPS возвращатель. Приборчик позволяющий выйти из леса в ту же точку из которой вошел в лес. Бум искать. Ну или вдруг удастся купить у кого-нибудь свежий гриб.
Александр , чем кроме цвета кожицы и желеобразного слоя отличается Веселка Адриана от Обыкновенной? Яйца большего размера?
|
|
Александр Дворянинов |
|
|
Зарегистрирован: 30.05.2012
Сообщения: 482
|

|
01-06-2012, 17:31 |
 Заголовок сообщения: |
| А.Ю. писал(а): |
| Александр , чем кроме цвета кожицы и желеобразного слоя отличается Веселка Адриана от Обыкновенной? Яйца большего размера? |
Я её видел только на фото.
Последний раз редактировалось: Александр Дворянинов (01-06-2012, 17:57), всего редактировалось 1 раз
|
|
Александр Кузнецов |
|
|
Зарегистрирован: 23.10.2009
Сообщения: 6770
Откуда: Алтайский край, р.ц.Алтайское
|

|
01-06-2012, 17:56 |
 Заголовок сообщения: |
| Александр Дворянинов писал(а): |
Обращаюсь к форуму!
Может кто то встречал в своём регионе, Весёлку Адриана?
. |
Похоже что Савелий у себя нашел Веселку Адриана. Мы с ним обсуждали этот вопрос. Но, он сейчас не выходит на связь. Появиться, может прояснит? Он и фото мне высылал. Очень даже похожа!
Такой же гриб (фото) мне помнится показывал Вячеслав (Paul). Так что похоже у Вячеслава тоже два вида: Веселка обыкновенная и В. Адриана.
Есть такая же, и даже более окрашенная у Виталия (Украина). Он даже фото выкладывал в теме "Удивительные грибы цветы", или в какой-то теме. Не помню. У него есть фотоальбом. http://my.mail.ru/my/search_people?q=%C2%E8%F2%E0%EB%E8%E9+%CF%EE%F5%EE%EB%FC%F7%F3%EA&st=search&head=1&search=%CD%E0%E9%F2%E8#photo=/mail/vitalii2012/5019/5021
Но, он тоже давно не выходил на связь..
Последний раз редактировалось: Александр Кузнецов (01-06-2012, 18:10), всего редактировалось 1 раз
|
|
Александр Кузнецов |
|
|
Зарегистрирован: 23.10.2009
Сообщения: 6770
Откуда: Алтайский край, р.ц.Алтайское
|

|
01-06-2012, 18:01 |
 Заголовок сообщения: |
| Александр Дворянинов писал(а): |
| Александр Кузнецов писал(а): |
| А в меду- запросто! |
Александр Иванович опишите пожалуйста, как Вы отпраляли в меду?
В каком ? И как отправлять в меду черенки? Можно ссылку где написано. |
Ссылки нет. Это давно было, просто на память легло однажды.. А потом стал этим пользоваться.
А отправлял просто. Уложил в пакет из толстого черного п/э, залил цветковым медом. Запаял. И отправил. Плодовое тело в меду не "выстрелило".
Так же можно отправлять и черенки. Хоть через экватор. У них прийдет весна, и они прививают. Или наоборот.. А черенки целехонькие..
|
|
Александр Кузнецов |
|
|
Зарегистрирован: 23.10.2009
Сообщения: 6770
Откуда: Алтайский край, р.ц.Алтайское
|

|
01-06-2012, 18:04 |
 Заголовок сообщения: |
| А.Ю. писал(а): |
Хорошая идея - банк грибов.
По ходу тоже буду пробовать получить мицелий из спор, тяжей и кусочков плодовых тел. К моменту прочтения этой темы я уже заготовил все необходимой для сооружения главбоквса - камеры позволяющей стерилизовать и проводить работы по заражению мицелием различные среды в стерильных условиях, так сказать лаборатория на столе. Очередь за малым - за самими грибами 
Жаль, у нас в Подмосковье Веселки хрящеватой вроде бы нет. А было бы хорошо если бы была, поскольку она начинает плодоносить раньше Веселки обыкновенной.. |
И Вам выслать для опытов?
А опыт-то работы есть с материалом? Или только желание?
|
|
Александр Дворянинов |
|
|
Зарегистрирован: 30.05.2012
Сообщения: 482
|

|
01-06-2012, 18:32 |
 Заголовок сообщения: |
Решил показать и рассказать, что у нас будет и в каком виде.

Так будет выглядеть, пакет с мицелим какой либо культуры, на зерновом носителе, применяется для засева на участке или в саду.

Так будет выглядеть, первичная маточная культыра, для засева сотен кг. зернового мицелия.

Так будет выглядеть, маточная культура на агаре, для использования профессионалами в лаборатории.
|
|
Александр Дворянинов |
|
|
Зарегистрирован: 30.05.2012
Сообщения: 482
|

|
01-06-2012, 18:39 |
 Заголовок сообщения: |
| Александр Кузнецов писал(а): |
| Так же можно отправлять и черенки. Хоть через экватор. У них прийдет весна, и они прививают. Или наоборот.. А черенки целехонькие.. |
Какого размера должны быть черенки, или правильнее сколько почек должно остаться на стебле?
|
|
Александр Кузнецов |
|
|
Зарегистрирован: 23.10.2009
Сообщения: 6770
Откуда: Алтайский край, р.ц.Алтайское
|

|
01-06-2012, 18:45 |
 Заголовок сообщения: |
Размер не определяющий фактор. Тут играет роль вызревание. Зеленый чернок мед высушит (обезводит). Я так думаю, опыты не ставил?
|
|
А.Ю. |
|
|
Зарегистрирован: 02.05.2011
Сообщения: 182
Откуда: Москва
|

|
01-06-2012, 18:47 |
 Заголовок сообщения: |
| Александр Кузнецов писал(а): |
И Вам выслать для опытов?
А опыт-то работы есть с материалом? Или только желание?
_________________ |
Опыта работы нет.
Желание есть. Проштудировано материала много. В том числе практиков выращивающих грибы в домашних условиях. Ну я писал на каких сайтах я почерпнул информацию.
Хочу попробовать вырастить на разных средах. Агар уже купил. Мед тоже. В качестве жидких сред используется и разбавленный мед в том числе.
Гарантии 100% успеха нет, но надежда что получится есть.
Вообще-то опыт некоторый есть - отрицательный. Прошлым летом пытался получить мицелий из спор, но прокололся со стерилизацией. В этом году подготовился более серьезно. Не получится, буду в следующем году. До победного.
Последний раз редактировалось: А.Ю. (01-06-2012, 18:48), всего редактировалось 1 раз
|
|
Александр Кузнецов |
|
|
Зарегистрирован: 23.10.2009
Сообщения: 6770
Откуда: Алтайский край, р.ц.Алтайское
|

|
01-06-2012, 18:48 |
 Заголовок сообщения: |
| Александр Дворянинов писал(а): |
Решил показать и рассказать, что у нас будет и в каком виде.
Так будет выглядеть, пакет с мицелим какой либо культуры, на зерновом носителе, применяется для засева на участке или в саду.
|
Какого количества достаточно для засева? В смысле размер кусочка, или целиком полностью весь пакет в одно место?
|
|
Александр Дворянинов |
|
|
Зарегистрирован: 30.05.2012
Сообщения: 482
|

|
01-06-2012, 19:06 |
 Заголовок сообщения: |
| Александр Кузнецов писал(а): |
| Какого количества достаточно для засева? В смысле размер кусочка, или целиком полностью весь пакет в одно место? |
Всё зависит от культуры которую засеваете , в принципе всё также как если Вы заражаете опилочным мицелием, эффект врастания будет эффективнее, пакет весит от 2.5 до 5 кг. в зависимости какой злак используется. Мицелий высевать, где хотите что бы появились грибы, достаточно горсти в одно место. Само собой разумеется, сапрофиты симбионты и микоризные нужно поселять к растениям и соответствующим деревьям
Последний раз редактировалось: Александр Дворянинов (01-06-2012, 20:37), всего редактировалось 1 раз
|
|
Дмитро |
|
|
Зарегистрирован: 27.10.2009
Сообщения: 684
Откуда: Донецк, Украина.
|

|
01-06-2012, 19:47 |
 Заголовок сообщения: |
Идея хорошая, но как к ней приобщиться жителю Украины?
Александр Иванович, как Вам Виталий из Украины посылку с мицелием отправлял?
И ещё вопрос. Почему-то весь разговор только о грибах в саду. А как относиться к грибам в лесах и лесопосадках?
У меня, например, пока разводить грибы на участке не получается. Всё, что растёт (кроме шампиньонов), растёт само. В то время как симбионты (рядовка фиолетовая, сыроежка, лисичка) в посадках растут, а у меня не хотят. Но ведь можно их насобирать и методом Александра (спорами, запечатанными в бумаге) отправить.
Кроме того, Александр говорил, что у него есть уже банк из 120 наименований, а в списке у него явно не 120.
Какие ещё есть?
Какие ещё интересуют?
Есть ли такие, которые совсем не интересуют?
_________________
С уважением,
Дмитрий.
|
|
|
|
|
|
|
 |
|
Вы не можете начинать темы
Вы не можете отвечать на сообщения
Вы не можете редактировать свои сообщения
Вы не можете удалять свои сообщения
Вы не можете голосовать в опросах
Вы не можете вкладывать файлы
Вы можете скачивать файлы
|
|
|